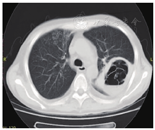

探讨肾移植术后肺部毛霉菌感染的发病原因、诊断与治疗。
回顾性分析2015年1月至2019年6月4例典型肺部毛霉菌感染病例,并结合国内外相关文献进行分析,以期对肾移植后肺部毛霉菌感染的发病时间、临床表现及其诊断、治疗进行总结分析。
4例引起严重临床症状受者中,3例受者经过及时的对症治疗后好转存活至今,1例因毛霉菌侵犯肺部血管引起血胸导致受者死亡。
肾移植术后肺部毛霉菌感染进展快,病情凶险,致死率高,及时停用或减量免疫抑制剂以及根据病情单用或联合使用针对毛霉菌的抗菌药物,是挽救受者生命的关键。

版权归中华医学会所有。
未经授权,不得转载、摘编本刊文章,不得使用本刊的版式设计。
除非特别声明,本刊刊出的所有文章不代表中华医学会和本刊编委会的观点。
肾移植术后肺部毛霉菌感染,如处理不及时,常导致受者死亡[1]。毛霉菌感染发病率低,但起病急骤、进展快,发病初期不易诊断,预后较差。随着肾移植手术的广泛发展,毛霉菌感染病例增加。因此,应给予重视,早诊断、早治疗,以降低死亡率[2,3]。我们回顾性分析了江西省人民医院于2015年1月至2019年6月4例典型肺部毛霉菌感染病例,并结合国内外相关文献进行分析,以期对肾移植后肺部毛霉菌感染的临床表现及其诊断、治疗进行总结分析,提高诊治水平。
4例肺部毛霉菌感染受者均为男性,年龄31~47岁,体重指数15.21~26.22 kg/m2,均为首次肾移植,供肾均来源死亡后器官捐献;肾移植时与供者ABO血型相符,HLA抗原错配数1~3个,淋巴细胞毒交叉配型3.0%~5.0%,群体反应性抗体均为阴性。4例受者的临床资料详见表1。

肾移植后肺部毛霉菌感染的临床资料
肾移植后肺部毛霉菌感染的临床资料
| 受者 | 供者住ICU时间 | 是否发生DGF | 是否使用ATG | 合并其他基础疾病 | 移植术后发病时间 | 发病时症状 | 免疫抑制方案调整 | 是否使用人免疫球蛋白 |
|---|---|---|---|---|---|---|---|---|
| 例1 | <1周 | 是 | 是 | 糖尿病 | 7个月 | 呼吸窘迫、胸痛、咯血 | 停用 | 是 |
| 例2 | >1周 | 否 | 否 | 无 | 第12天 | 呼吸窘迫 | 减量 | 是 |
| 例3 | >1周 | 是 | 是 | 无 | 第8天 | 咯血 | 减量 | 是 |
| 例4 | >1周 | 否 | 否 | 糖尿病 | 3个月 | 呼吸窘迫、胸痛、咯血 | 停用 | 是 |
| 受者 | 是否使用呼吸机 | 是否采用支气管镜检 | 是否经皮肺穿刺活检 | 肺泡灌洗液或活检病理结果 | 治疗药物 | 手术治疗 | 愈后 |
|---|---|---|---|---|---|---|---|
| 例1 | 是 | 是 | 是 | 毛霉菌 | 两性霉素B脂质体、氟胞嘧啶 | 移植肾周血肿清除及表面结扎止血 | 好转出院 |
| 例2 | 是 | 是 | 否 | 毛霉菌 | 泊沙康唑 | 好转出院 | |
| 例3 | 否 | 是 | 否 | 毛霉菌 | 两性霉素B脂质体、泊沙康唑 | 好转出院 | |
| 例4 | 是 | 是 | 是 | 毛霉菌 | 两性霉素B脂质体 | 血胸导致死亡 |
肾移植术后4例受者均使用了甲泼尼龙500 mg/d,连用3 d,免疫抑制维持期采用他克莫司+吗替麦考酚酯(MMF)+泼尼松。他克莫司起始剂量为0.10~0.15 mg·kg-1·d-1,根据血药浓度调整他克莫司剂量,术后6个月内将血他克莫司浓度谷值维持在8~12 μg/L,6个月后维持在8~10 μg/L,1年后维持在5~8 μg/L;MMF起始剂量为1.0~1.5 g/d,维持剂量为1.0 g/d;泼尼松起始剂量为50 mg/d,每5天递减10 mg,至10 mg/d维持。视供肾及受者术后恢复情况予以抗胸腺细胞球蛋白(ATG)行免疫诱导及治疗。ATG诱导50 mg/d,治疗100 mg/d,连用3~5 d,视肾功能恢复情况及体重情况延长1~2 d。
例1 术后早期发生移植物功能恢复延迟(DGF),予以ATG治疗后恢复顺利,出院。术后7个月时因发热、呼吸窘迫入院,入院后予以无创呼吸机辅助呼吸,开始大包围治疗(美罗培南、替考拉宁、伏立康唑、复方新诺明片、更昔洛韦、异烟肼、利福平、乙胺丁醇、吡嗪酰胺等),并加用免疫球蛋白提升免疫力治疗。入院第3周受者出现胸痛、咯血,复查肺部CT,原左肺上叶实变病灶中出现空洞(图1),考虑曲霉空洞,重点予以伏立康唑抗曲霉治疗;复查肺部CT提示空洞较前增大,受者症状继续加重未能缓解,后行经皮肺穿刺活检提示空洞为毛霉菌病,遂予以两性霉素B脂质体(逐日递增至维持剂量1 mg·kg-1·d-1)及氟胞嘧啶(4 g/d),1周后复查肺部CT提示左肺空洞稍有增大,考虑毛霉菌感染未得到控制,将两性霉素B脂质体用量逐渐增大到2 mg·kg-1·d-1(100 mg/d),予以两性霉素B脂质体治疗22 d时复查CT,空洞缩小,此时免疫抑制剂尚未完全恢复,仅口服甲泼尼龙(12 mg/d)。受者回当地医院继续两性霉素B脂质体及氟胞嘧啶治疗至痊愈,整个治疗过程中停用他克莫司70 d,停用MMF121 d后改咪唑立宾,两性霉素B脂质体共使用65 d(100 mg/d治疗35 d后根据复查肺部CT检查及肾功能情况逐渐递减为60 mg/d、20 mg/d至停用),治疗过程中尿量基本正常,血肌酐波动于130~203 mmol/L,治疗结束后45 d复查血肌酐处于正常范围,未发生排斥反应。


例2 术后尿量理想,血肌酐恢复良好,术后第9天出现右侧腰背部胀痛,CT检查提示移植肾周大量血肿,予以反复输注红细胞后血红蛋白仍进行性下降,移植肾区饱满,右侧腰背部可见皮肤瘀斑,移植肾区有压痛及叩击痛,考虑存在活动性出血,遂急诊行探查止血及移植肾周血肿清除术,术中采集标本送检未见阳性发现;肾移植术后第12天(二次手术后第3天)受者开始出现呼吸急促、呼吸衰竭,无创呼吸机辅助呼吸条件下血氧难以维持,遂转往重症治疗科行气管插管呼吸机辅助呼吸,在重症治疗科治疗3 d后受者拔除气管插管转回我科继续治疗,行床旁纤支镜检查,于各级支气管内给予吸痰和肺泡灌洗术,肺泡灌洗液检查提示生长毛霉菌,肺部CT检查提示右肺上叶空洞,遂予以泊沙康唑(20 ml/d)餐中口服抗真菌治疗,他克莫司按正常剂量1/3口服,MMF减量为0.5 g/d,出院前(肾移植术后44 d)复查CT提示右肺上叶空洞病灶吸收好转,移植肾周血肿范围较前明显减少,切口愈合良好。出院后继续口服泊沙康唑抗真菌治疗,术后75 d复查肺部CT提示病灶完全吸收,MMF逐渐加量至正常剂量。整个治疗过程中,他克莫司均按正常剂量1/3口服,血他克莫司浓度控制在5~8 μg/L,共使用泊沙康唑(20 ml/d)60 d,尿量、肾功能、尿常规均恢复正常。
例3 与例2为同一供肾来源,术后受者出现DGF,予以ATG抗排斥反应治疗5 d;术后第8天开始出现咳嗽,咯咖啡色浓痰,痰培养显示涂片丝状真菌(+),生长毛霉菌;术后第9天首次行纤维支气管镜检查显示右中下肺支气管内见大量灰白色物质覆盖(图2),肺泡灌洗液培养涂片提示毛霉菌感染(图3),纤维支气管镜下组织活检病理报告诊断:"右中间支气管"支气管黏膜慢性炎并毛霉菌菌落(图4),加用两性霉素B脂质体(逐日递增至维持剂量1 mg·kg-1·d-1)抗真菌治疗;术后第35天复查纤维支气管镜检查显示,右主支气管及右中下叶支气管见灰白色异生物堵塞(图5),遂在纤维支气管镜下行氮气刀治疗半小时,并加服泊沙康唑(20 ml/d)抗真菌治疗;术后第42天纤维支气管镜下第2次行氮气刀治疗,较第一次氮气刀治疗相比堵塞处有所通畅。经过二次氮气刀治疗后术后第49天复查纤维支气管镜检查提示,原堵塞处未见明显异生物,较前明显通畅;术后53 d受者经纤维支气管镜亚氮刀治疗后病灶基本吸收,出院。出院后受者继续口服泊沙康唑抗真菌治疗,MMF从0.5 mg/d逐渐加量恢复至正常剂量。整个治疗过程中,他克莫司均按正常剂量1/3口服,血他克莫司浓度控制于5~8 μg/L,两性霉素B脂质体共使用32 d,泊沙康唑共使用90 d,治疗期间尿量基本正常,血肌酐波动于98~157 mmol/L,未发生排斥反应。






例4 受者术后恢复良好,顺利出院。于术后3个月因胸痛入院,肺部CT检查提示右肺上叶出现团块状实变影(图6、图7),已侵犯肺血管,入院第3天行经皮肺穿刺活检,活检病理提示右下肺真菌感染(毛霉菌感染倾向),加用两性霉素B脂质体(逐日递增至维持剂量1 mg·kg-1·d-1)抗感染治疗;入院第4天受者出现胸闷、胸痛加重伴有咯血,床旁胸部X线片检查提示右侧胸腔积液,予以胸腔闭式引流术,引出红色血性胸水约150 ml;第5天晚胸闷、胸痛症状进一步加重,并出现血压、心率、血氧下降,血胸最终导致受者死亡。受者病情进展快、病情凶险,考虑系毛霉菌容易侵犯血管所致血胸最终导致受者死亡。


肾移植受者术后长期服用免疫抑制剂,导致受者机体免疫力低下,且术后高起点、长疗程广谱抗生素的不合理应用,造成体内菌群失调,为毛霉菌的增殖、蔓延创造了条件。本组病例中,有2例原发病是糖尿病肾病行肾移植术,术后因出现DGF予以ATG加强抗排斥治疗,极大地增加了毛霉菌感染发生几率。因此,对于这些受者所发生的感染,应该给予重视,早诊断、早治疗,降低死亡率。
肾移植术后肺部毛霉菌感染的来源需重点考虑供肾隐性感染可能,如供者长期ICU环境及广谱抗生素的应用、器官获取过程中保存液或保存装置污染、获取过程中肠道破口来源感染、尿道吻合口,尿路逆行感染等。对于存在潜在感染或明确感染者尽量不考虑作为供者,必要时可对供者进行广泛的微生物感染筛选:术中留取血液、尿液及移植血管组织,送培养或病理检查。对于器官保存液常规培养,根据标本阳性结果给予敏感药物抗感染治疗,但不排外部分病原学检查出现假阴性可能。若明确感染来源为供肾,应及早切除,避免感染播散全身。本组病例中,例2及例3为同一供肾来源,需高度警惕供肾来源毛霉菌感染,尤其是例2围手术期合并有移植肾周血肿表现,但根据探查术中未见动脉吻合口毛霉菌感染表现,且送检未见阳性发现,最后确诊毛霉菌感染均是通过肺部标本送检,并根据确诊结果及时予以对症有效治疗,并好转出院。
肾移植受者发生侵袭性真菌感染的易感时间分为三个阶段:术后1个月内、术后1~6个月及半年后[7,8]。本组4例受者肺部毛霉菌感染发生时间有3例在术后3个月内,1例在术后第7个月,确诊主要是通过支气管镜检、肺泡灌洗液培养、经皮肺穿刺活检等方法,鉴于其临床表现的不典型性,诊断又大都依赖有创的组织病理学检查,移植医师对此应有一定的认知及警觉性。由于毛霉菌嗜血管性生长,极易侵犯肺脏大血管,在行经皮肺穿刺活检时需格外小心,术前需认真阅片,加强术前风险评估。例4从肺部CT检查中可以清晰看出病灶已侵犯肺脏动脉,穿刺后需重点注意有无胸闷、胸痛、血胸等表现,一旦毛霉菌侵犯大血管致其破裂,可引起胸腔大出血导致受者死亡。
肾移植术后重症肺部感染早期可出现低氧血症,若单纯吸氧或面罩给氧条件下不能改善供氧状况时应尽早使用呼吸机[9]。本组病例中,例1使用无创呼吸机辅助呼吸,例2及例4使用气管插管呼吸机辅助呼吸,为后续进一步治疗争取了时间。
大包围治疗方法可以早期迅速控制病情,确实救治了大量患者,但治疗费用高,无法明确究竟是哪个药物起作用,如何早期明确病原体很重要,尤其是对于肾移植术后肺部侵袭性真菌感染,真菌鉴定到种属特别重要。例1因为早期未能明确病原体,不能针对毛霉菌用药,导致病情急剧发展,空洞逐渐增大,这也是给我们的一个经验及教训。对于肺部毛霉菌感染目前首选两性霉素B及其脂质体剂治疗[15],亦可根据病情联合棘白菌素、泊沙康唑等治疗提高毛霉菌感染的治愈率,泊沙康唑因药物动力不稳定,不推荐作为起始治疗的一线用药,主要用于二线挽救性治疗用药。对于肺部毛霉菌感染,目前药物治疗可以起到较好作用,推荐首选两性霉素B脂质体(逐日递增至维持剂量1 mg·kg-1·d-1)治疗,治疗时间无明确定论,但建议治疗至感染消退或所有的临床和影像学表现稳定,一般需要6~12周[15]。本组病例主要根据临床症状及复查影像学决定使用时间(均大于6周),予以抗感染治疗的同时纤维支气管镜氮气刀手术切除局部肺脏病灶能否作为选择方案还值得商榷。本组病例中,例3采用了两性霉素B脂质体及泊沙康唑联合用药,其他3例为单药治疗。对于肾移植后肺部毛霉菌感染的治疗,我院目前已成立移植科、呼吸科、检验科、重症医学科、临床药学部联合诊疗组,将在临床深入开展CYP3A5基因多态性检测指导术后个体化用药,完善T淋巴细胞亚群检测行免疫状态的评估[16],早期应用纤维支气管镜检联合肺泡灌洗明确病原体[17],进一步提高肾移植后肺部毛霉菌感染的诊疗水平。
所有作者均声明不存在利益冲突